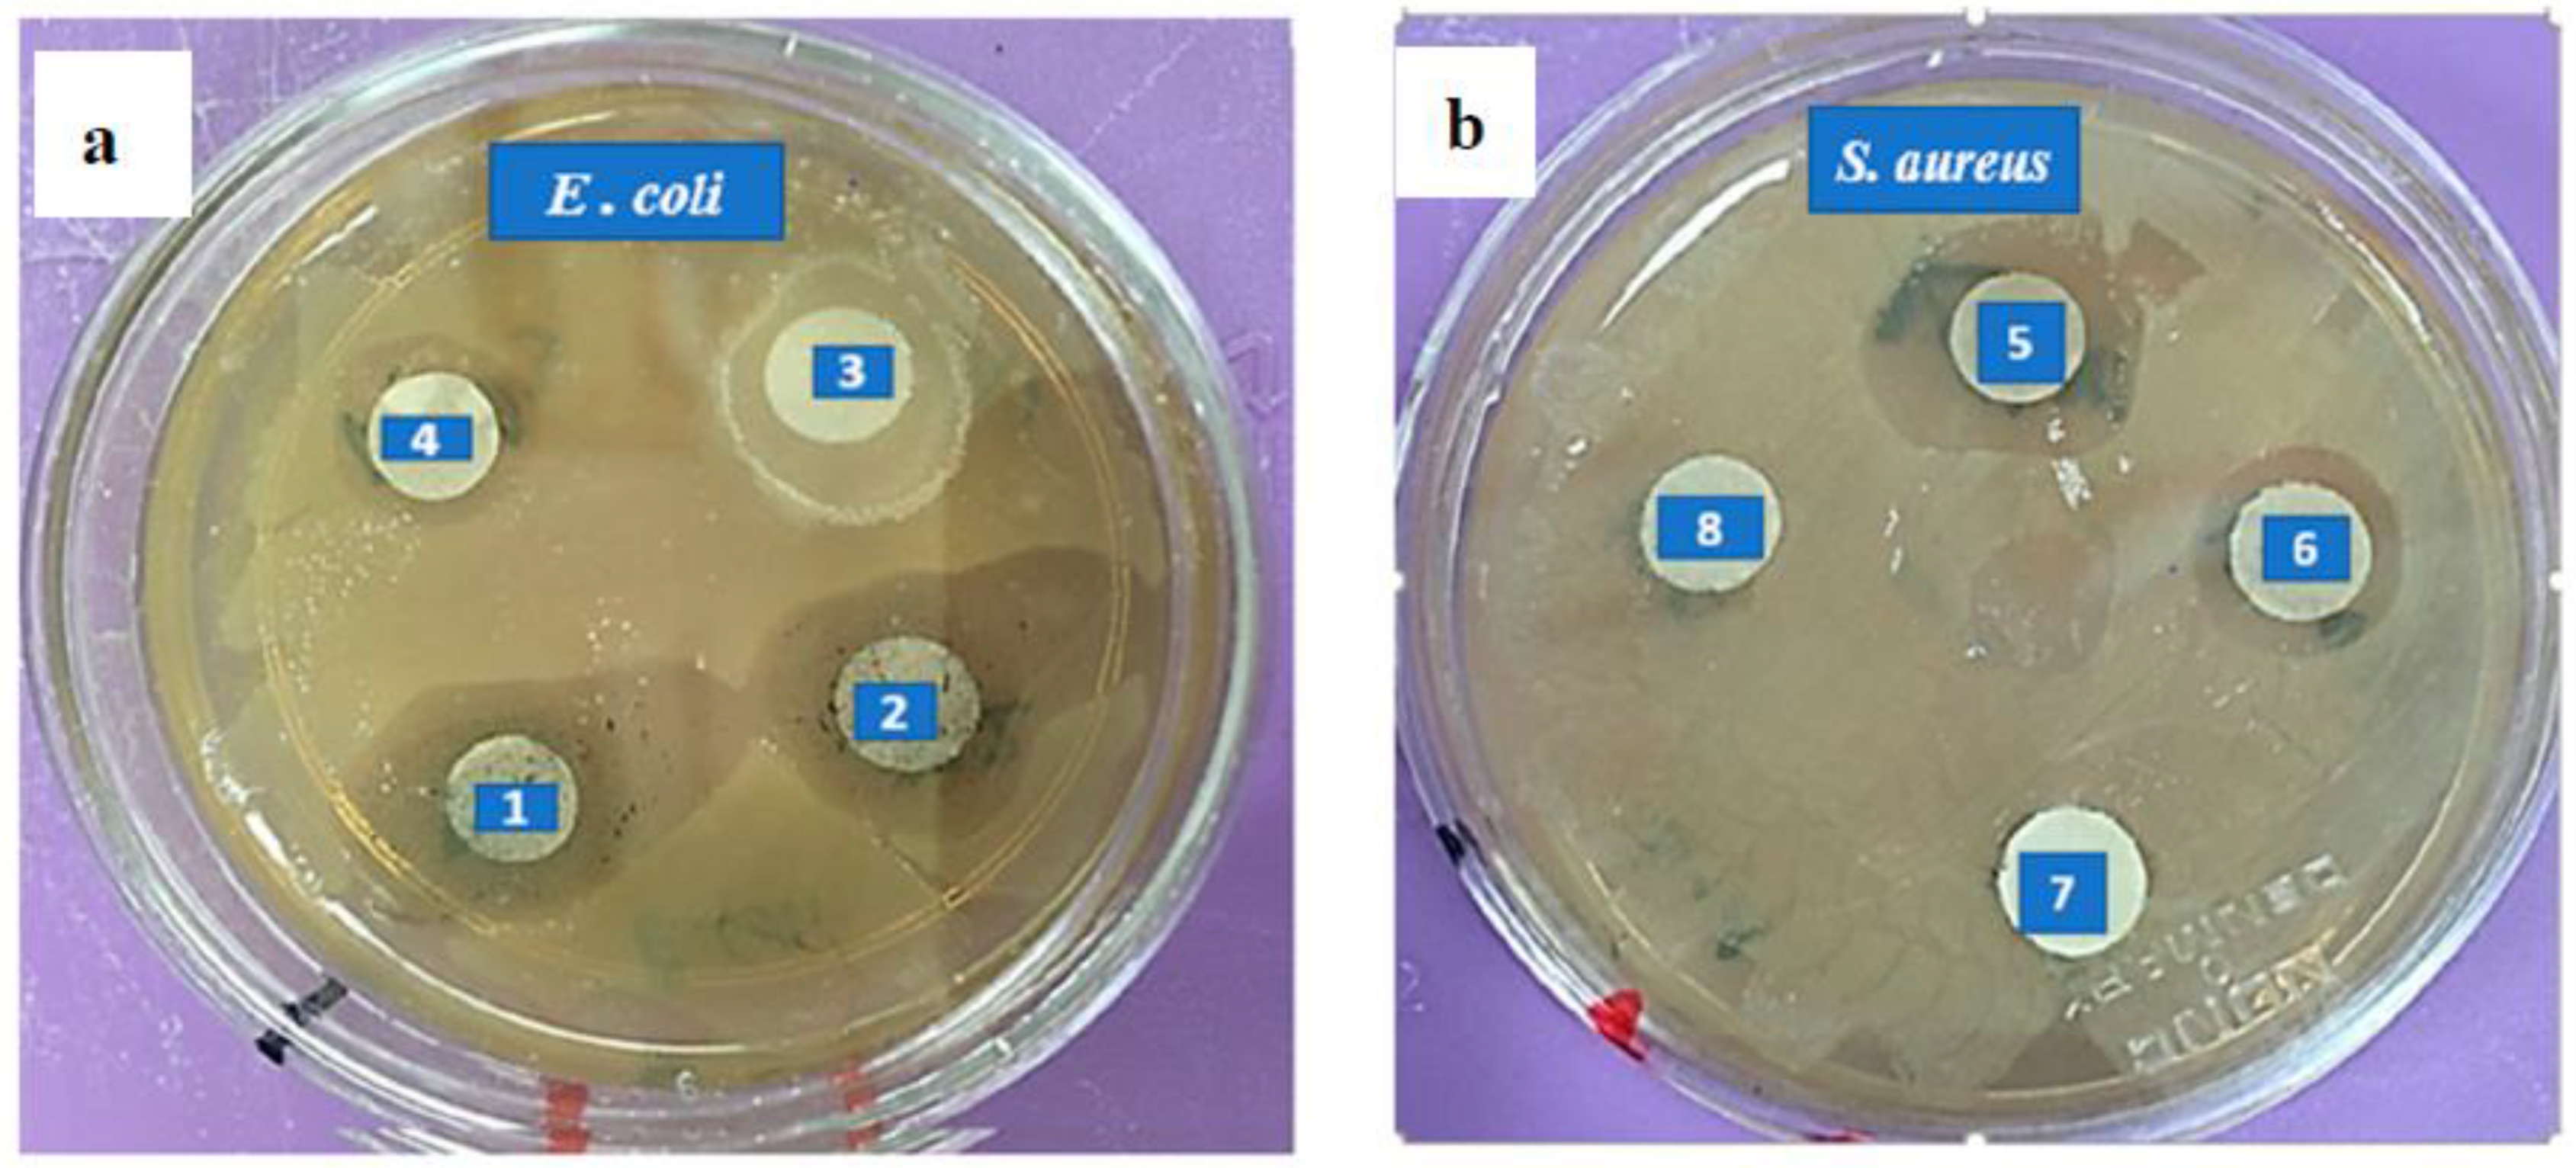
Biomolecules 13 01054 g008

Bioinspired Synthesis of Silver Nanoparticles for the Remediation of Toxic Pollutants and Enhanced Antibacterial Activity
Abstract
1. Introduction
2. Materials and Method
2.1. Chemicals
2.2. Preparation of Nanobiocomposites
2.3. Nonaobiocomposite Characterization
2.4. Batch Adsorption Studies
2.5. Desorption and Reusability Study
2.6. Antibacterial Test (MIC and MBC)
3. Results and Discussion
3.1. UV/Vis Spectroscopy
3.2. Scanning Electron Microscopy (SEM)
3.3. Fourier Transform Infrared Spectroscopy (FTIR)
3.4. Batch Adsorption Study
3.4.1. Effect of pH
3.4.2. Effect of Contact Time
3.4.3. Effect of Temperature
3.4.4. Effect of Adsorbent Dosage
3.4.5. Effect of Adsorbate Concentration
3.5. Isotherm Studies
3.5.1. Adsorption Kinetics
3.5.2. Adsorption Isotherm
3.5.3. Thermodynamic Studies
3.6. Reusability
3.7. Antibacterial Efficacy
3.8. Comparison Study
4. Conclusions
Author Contributions
Funding
Institutional Review Board Statement
Informed Consent Statement
Data Availability Statement
Acknowledgments
Conflicts of Interest
References
- Wu, Y.; Chen, L.; Long, X.; Zhang, X.; Pan, B.; Qian, J. Multi-functional magnetic water purifier for disinfection and removal of dyes and metal ions with superior reusability. J. Hazard. Mater. 2018, 347, 160–167. [Google Scholar] [CrossRef]
- Mauter, M.S.; Zucker, I.; Perreault, F.; Werber, J.R.; Kim, J.H.; Elimelech, M. The role of nanotechnology in tackling global water challenges. Nat. Sustain. 2018, 1, 166–175. [Google Scholar] [CrossRef]
- Aghalari, Z.; Dahms, H.U.; Sillanpää, M.; Sosa-Hernandez, J.E.; Parra-Saldívar, R. Effectiveness of wastewater treatment systems in removing microbial agents: A systematic review. Glob. Health 2020, 16, 13. [Google Scholar] [CrossRef] [PubMed]
- Cheng, S.; Liu, Y.; Xing, B.; Qin, X.; Zhang, C.; Xia, H. Lead and cadmium clean removal from wastewater by sustainable biochar derived from poplar saw dust. J. Clean. Prod. 2021, 314, 128074. [Google Scholar] [CrossRef]
- Agency for Toxic Substances and Disease Registry (ATSDR). Toxicological Profile for Lead (Draft for Public Comment); U.S. Department of Health and Human Services, Public Health Service: Atlanta, GA, USA, 2019. [Google Scholar]
- Mane, P.V.; Patil, P.; Mahishi, A.A.; Kigga, M.; Bhat, M.P.; Lee, K.H.; Kurkuri, M. Rhodamine 6G derivative for the selective copper detection and remediation using nanoporous diatomaceous earth-engineered functional receptor. Heliyon 2023, 9, e16600. [Google Scholar] [CrossRef]
- Chatterjee, S.; Lee, D.S.; Lee, M.W.; Woo, S.H. Enhanced adsorption of congo red from aqueous solutions by chitosan hydrogel beads impregnated with cetyl trimethyl ammonium bromide. Bioresour. Technol. 2009, 100, 2803. [Google Scholar] [CrossRef]
- Mittal, A.; Mittal, J.; Malviya, A.; Gupta, V.K. Adsorptive removal of hazardous anionic dye “Congo red” from wastewater using waste materials and recovery by desorption. J. Colloid Interface Sci. 2009, 340, 16–26. [Google Scholar] [CrossRef]
- Aryee, A.A.; Dovi, E.; Li, Q.; Han, R.; Li, Z.; Qu, L. Magnetic biocomposite based on peanut husk for adsorption of hexavalent chromium, Congo red and phosphate from solution: Characterization, kinetics, equilibrium, mechanism and antibacterial studies. Chemosphere 2022, 287, 132030. [Google Scholar] [CrossRef] [PubMed]
- Suazo-Hernández, J.; Sepúlveda, P.; Cáceres-Jensen, L.; Castro-Rojas, J.; Poblete-Grant, P.; Bolan, N.; Mora, M.D.L.L. nZVI-Based Nanomaterials Used for Phosphate Removal from Aquatic Systems. Nanomaterials 2023, 13, 399. [Google Scholar] [CrossRef] [PubMed]
- Zamora-Ledezma, C.; Negrete-Bolagay, D.; Figueroa, F.; Zamora-Ledezma, E.; Ni, M.; Alexis, F.; Guerrero, V.H. Heavy metal water pollution: A fresh look about hazards, novel and conventional remediation methods. Environ. Technol. Innov. 2021, 22, 101504. [Google Scholar] [CrossRef]
- Ying, Y.; He, P.; Ding, G.; Peng, X. Ultrafast adsorption and selective desorption of aqueous aromatic dyes by graphene sheets modified by graphene quantum dots. Nanotechnology 2016, 27, 245703. [Google Scholar] [CrossRef]
- Rafiq, A.; Ikram, M.; Ali, S.; Niaz, F.; Khan, M.; Khan, Q.; Maqbool, M. Photocatalytic degradation of dyes using semiconductor photocatalysts to clean industrial water pollution. J. Ind. Eng. Chem. 2021, 97, 111–128. [Google Scholar] [CrossRef]
- Ihaddaden, S.; Aberkane, D.; Boukerroui, A.; Robert, D. Removal of methylene blue (basic dye) by coagulation-flocculation with biomaterials (bentonite and Opuntia ficus indica). J. Water Process Eng. 2022, 49, 102952. [Google Scholar] [CrossRef]
- Piaskowski, K.; Świderska-Dąbrowska, R.; Zarzycki, P.K. Dye removal from water and wastewater using various physical, chemical, and biological processes. J. AOAC Int. 2018, 101, 1371–1384. [Google Scholar] [CrossRef]
- Afkhami, A.; Moosavi, R. Adsorptive removal of Congo red, a carcinogenic textile dye, from aqueous solutions by maghemite nanoparticles. J. Hazard. Mater. 2010, 174, 398–403. [Google Scholar] [CrossRef] [PubMed]
- Ferrarini, F.; Bonetto, L.R.; Crespo, J.S.; Giovanela, M. Removal of Congo red dye from aqueous solutions using a halloysite-magnetite-based composite. Water Sci. Technol. 2016, 73, 2132–2142. [Google Scholar] [CrossRef] [PubMed]
- Xu, X.; Gao, B.; Jin, B.; Yue, Q. Removal of anionic pollutants from liquids by biomass materials: A review. J. Mol. Liq. 2016, 215, 565–595. [Google Scholar] [CrossRef]
- Chakraborty, R.; Asthana, A.; Singh, A.K.; Jain, B.; Susan, A.B.H. Adsorption of heavy metal ions by various low-cost adsorbents: A review. Int. J. Environ. Anal. Chem. 2022, 102, 342–379. [Google Scholar] [CrossRef]
- Aryee, A.A.; Mpatani, F.M.; Kani, A.N.; Dovi, E.; Han, R.; Li, Z.; Qu, L. A review on functionalized adsorbents based on peanut husk for the sequestration of pollutants in wastewater: Modification methods and adsorption study. J. Clean. Prod. 2021, 310, 127502. [Google Scholar] [CrossRef]
- Wong, S.; Ngadi, N.; Inuwa, I.M.; Hassan, O. Recent advances in applications of activated carbon from biowaste for wastewater treatment: A short review. J. Clean. Prod. 2018, 175, 361–375. [Google Scholar] [CrossRef]
- Tan, X.F.; Liu, S.B.; Liu, Y.G.; Gu, Y.L.; Zeng, G.M.; Hu, X.J.; Liu, S.-H.; Jiang, L.H. Biochar as potential sustainable precursors for activated carbon production: Multiple applications in environmental protection and energy storage. Bioresour. Technol. 2017, 227, 359–372. [Google Scholar] [CrossRef]
- Idan, I.J.; Jamil, S.N.A.B.M.; Abdullah, L.C.; Choong, T.S.Y. Removal of reactive anionic dyes from binary solutions by adsorption onto quaternized kenaf core fiber. Int. J. Chem. Eng. 2017, 2017, 9792657. [Google Scholar] [CrossRef]
- Dai, Y.; Sun, Q.; Wang, W.; Lu, L.; Liu, M.; Li, J.; Yang, S. Utilizations of agricultural waste as adsorbent for the removal of contaminants: A review. Chemosphere 2018, 211, 235–253. [Google Scholar] [CrossRef] [PubMed]
- Morin-Crini, N.; Loiacono, S.; Placet, V.; Torri, G.; Bradu, C.; Kostić, M.; Cosentino, C.; Chanet, G.; Martel, B.; Lichtfouse, E.; et al. Hemp-based adsorbents for sequestration of metals: A review. Environ. Chem. Lett. 2019, 17, 393–408. [Google Scholar] [CrossRef]
- Freitas, J.V.; Nogueira, F.G.; Farinas, C.S. Coconut shell activated carbon as an alternative adsorbent of inhibitors from lignocellulosic biomass pretreatment. Ind. Crop. Prod. 2019, 137, 16–23. [Google Scholar] [CrossRef]
- Sethy, T.R.; Biswal, T.; Sahoo, P.K. An indigenous tool for the adsorption of rare earth metal ions from the spent magnet e-waste: An eco-friendly chitosan biopolymer nanocomposite hydrogel. Sep. Purif. Technol. 2023, 309, 122935. [Google Scholar] [CrossRef]
- Abd Malek, N.N.; Jawad, A.H.; Ismail, K.; Razuan, R.; ALOthman, Z.A. Fly ash modified magnetic chitosan-polyvinyl alcohol blend for reactive orange 16 dye removal: Adsorption parametric optimization. Int. J. Biol. Macromol. 2021, 189, 464–476. [Google Scholar] [CrossRef]
- Hachicho, N.; Hoffmann, P.; Ahlert, K.; Heipieper, H.J. Effect of silver nanoparticles and silver ions on growth and adaptive response mechanisms of Pseudomonas putida mt-2. FEMS Microbiol. Lett. 2014, 355, 71–77. [Google Scholar] [CrossRef]
- Zhang, F.; Lan, J.; Zhao, Z.; Yang, Y.; Tan, R.; Song, W. Removal of heavy metal ions from aqueous solution using Fe3O4–SiO2-poly (1, 2-diaminobenzene) core–shell sub-micron particles. J. Colloid Interface Sci. 2012, 387, 205–212. [Google Scholar] [CrossRef]
- Huang, L.; He, M.; Chen, B.; Hu, B. Magnetic Zr-MOFs nanocomposites for rapid removal of heavy metal ions and dyes from water. Chemosphere 2018, 199, 435–444. [Google Scholar] [CrossRef]
- Akhigbe, L.; Ouki, S.; Saroj, D. Disinfection and removal performance for Escherichia coli and heavy metals by silver-modified zeolite in a fixed bed column. Chem. Eng. J. 2016, 295, 92–98. [Google Scholar] [CrossRef]
- Hasfalina, C.M.; Maryam, R.Z.; Luqman, C.A.; Rashid, M. The potential use of kenaf as a bioadsorbent for the removal of copper and nickel from single and binary aqueous solution. J. Nat. Fibers 2010, 7, 267–275. [Google Scholar] [CrossRef]
- Sajab, M.S.; Chia, C.H.; Zakaria, S.; Jani, S.M.; Ayob, M.K.; Chee, K.L.; Khiew, P.S.; Chiu, W.S. Citric acid modified kenaf core fibres for removal of methylene blue from aqueous solution. Bioresour. Technol. 2011, 102, 7237–7243. [Google Scholar] [CrossRef]
- Mandal, S.; Marpu, S.B.; Omary, M.A.; Dinulescu, C.C.; Prybutok, V.; Shi, S.Q. Lignocellulosic-Based Activated Carbon-Loaded Silver Nanoparticles and Chitosan for Efficient Removal of Cadmium and Optimization Using Response Surface Methodology. Materials 2022, 15, 8901. [Google Scholar] [CrossRef] [PubMed]
- Benkova, M.; Soukup, O.; Marek, J. Antimicrobial susceptibility testing: Currently used methods and devices and the near future in clinical practice. J. Appl. Microbiol. 2020, 129, 806–822. [Google Scholar] [CrossRef] [PubMed]
- H Moreno, P.R.; da Costa-Issa, F.; Rajca-Ferreira, A.K.; Pereira, M.A.; Kaneko, T.M. Native Brazilian plants against nosocomial infections: A critical review on their potential and the antimicrobial methodology. Curr. Top. Med. Chem. 2013, 13, 3040–3078. [Google Scholar] [CrossRef] [PubMed]
- Adnan, M.; Azad, M.O.K.; Madhusudhan, A.; Saravanakumar, K.; Hu, X.; Wang, M.H.; Ha, C.D. Simple and cleaner system of silver nanoparticle synthesis using kenaf seed and revealing its anticancer and antimicrobial potential. Nanotechnology 2020, 31, 265101. [Google Scholar] [CrossRef]
- Bar, H.; Bhui, D.K.; Sahoo, G.P.; Sarkar, P.; De, S.P.; Misra, A. Green synthesis of silver nanoparticles using latex of Jatropha curcas. Colloids Surf. A Physicochem. Eng. Asp. 2009, 339, 134–139. [Google Scholar] [CrossRef]
- Jayamani, E.; Loong, T.G.; Bakri, M.K.B. Comparative study of Fourier transform infrared spectroscopy (FTIR) analysis of natural fibres treated with chemical, physical and biological methods. Polym. Bull. 2020, 77, 1605–1629. [Google Scholar] [CrossRef]
- Saeed, A.A.H.; Harun, N.Y.; Sufian, S.; Bilad, M.R.; Zakaria, Z.Y.; Jagaba, A.H.; Ghaleb, A.A.S.; Mohammed, H.G. Pristine and magnetic kenaf fiber biochar for Cd2+ adsorption from aqueous solution. Int. J. Environ. Res. Public Health 2021, 18, 7949. [Google Scholar] [CrossRef]
- Aber, S.; Khataee, A.; Sheydaei, M. Optimization of activated carbon fiber preparation from Kenaf using K2HPO4 as chemical activator for adsorption of phenolic compounds. Bioresour. Technol. 2009, 100, 6586–6591. [Google Scholar] [CrossRef] [PubMed]
- Arami, M.; Limaee, N.Y.; Mahmoodi, N.M. Investigation on the adsorption capability of egg shell membrane towards model textile dyes. Chemosphere 2006, 65, 1999–2008. [Google Scholar] [CrossRef] [PubMed]
- Ali, M.E.; Yong, C.K.; Ching, Y.C.; Chuah, C.H.; Liou, N.S. Effect of single and double stage chemically treated kenaf fibers on mechanical properties of polyvinyl alcohol film. BioResources 2015, 10, 822–838. [Google Scholar] [CrossRef]
- Zhang, J.; Gao, J.; Chen, Y.; Hao, X.; Jin, X. Characterization, preparation, and reaction mechanism of hemp stem based activated carbon. Results Phys. 2017, 7, 1628–1633. [Google Scholar] [CrossRef]
- Tang, C.; Hu, D.; Cao, Q.; Yan, W.; Xing, B. Silver nanoparticles-loaded activated carbon fibers using chitosan as binding agent: Preparation, mechanism, and their antibacterial activity. Appl. Surf. Sci. 2017, 394, 457–465. [Google Scholar] [CrossRef]
- Govindan, S.; Nivethaa, E.A.K.; Saravanan, R.; Narayanan, V.; Stephen, A. Synthesis and characterization of chitosan–silver nanocomposite. Appl. Nanosci. 2012, 2, 299–303. [Google Scholar] [CrossRef]
- Hajji, S.; Khedir, S.B.; Hamza-Mnif, I.; Hamdi, M.; Jedidi, I.; Kallel, R.; Boufi, S.; Nasri, M. Biomedical potential of chitosan-silver nanoparticles with special reference to antioxidant, antibacterial, hemolytic and in vivo cutaneous wound healing. Biochim. Biophys. Acta (BBA)-Gen. Subj. 2019, 1863, 241–254. [Google Scholar] [CrossRef]
- Ghaedi, M.; Biyareh, M.N.; Kokhdan, S.N.; Shamsaldini, S.; Sahraei, R.; Daneshfar, A.; Shahriyar, S. Comparison of the efficiency of palladium and silver nanoparticles loaded on activated carbon and zinc oxide nanorods loaded on activated carbon as new adsorbents for removal of Congo red from aqueous solution: Kinetic and isotherm study. Mater. Sci. Eng. C 2012, 32, 725–734. [Google Scholar] [CrossRef]
- Leyva-Ramos, R.; Bernal-Jacome, L.A.; Acosta-Rodriguez, I. Adsorption of cadmium (II) from aqueous solution on natural and oxidized corncob. Sep. Purif. Technol. 2005, 45, 41–49. [Google Scholar] [CrossRef]
- Cuppett, J.D.; Duncan, S.E.; Dietrich, A.M. Evaluation of copper speciation and water quality factors that affect aqueous copper tasting response. Chem. Senses 2006, 31, 689–697. [Google Scholar] [CrossRef]
- Adolph, M.A.; Xavier, Y.M.; Kriveshini, P.; Rui, K. Phosphine functionalised multiwalled carbon nanotubes: A new adsorbent for the removal of nickel from aqueous solution. J. Environ. Sci. 2012, 24, 1133–1141. [Google Scholar] [CrossRef]
- Salam, M.A.; Al-Zhrani, G.; Kosa, S.A. Simultaneous removal of copper (II), lead (II), zinc (II) and cadmium (II) from aqueous solutions by multi-walled carbon nanotubes. Comptes Rendus Chim. 2012, 15, 398–408. [Google Scholar] [CrossRef]
- Abdelaziz, M.A.; Owda, M.E.; Abouzeid, R.E.; Alaysuy, O.; Mohamed, E.I. Kinetics, isotherms, and mechanism of removing cationic and anionic dyes from aqueous solutions using chitosan/magnetite/silver nanoparticles. Int. J. Biol. Macromol. 2023, 225, 1462–1475. [Google Scholar] [CrossRef] [PubMed]
- Ali, M.H.; Goher, M.E.; Al-Afify, A.D.; El-Sayed, S.M. A facile method for synthesis rGO/Ag nanocomposite and its uses for enhancing photocatalytic degradation of Congo red dye. SN Appl. Sci. 2022, 4, 276. [Google Scholar] [CrossRef]
- Yang, S.; Li, J.; Shao, D.; Hu, J.; Wang, X. Adsorption of Ni (II) on oxidized multi-walled carbon nanotubes: Effect of contact time, pH, foreign ions and PAA. J. Hazard. Mater. 2009, 166, 109–116. [Google Scholar] [CrossRef]
- Dawood, S.; Sen, T.K. Removal of anionic dye Congo red from aqueous solution by raw pine and acid-treated pine cone powder as adsorbent: Equilibrium, thermodynamic, kinetics, mechanism and process design. Water Res. 2012, 46, 1933–1946. [Google Scholar] [CrossRef]
- Si, Y.; Li, J.; Cui, B.; Tang, D.; Yang, L.; Murugadoss, V.; Maganti, S.; Huang, M.; Guo, Z. Janus phenol–formaldehyde resin and periodic mesoporous organic silica nanoadsorbent for the removal of heavy metal ions and organic dyes from polluted water. Adv. Compos. Hybrid Mater. 2022, 5, 1180–1195. [Google Scholar] [CrossRef]
- Liu, B.; Du, C.; Chen, J.J.; Zhai, J.Y.; Wang, Y.; Li, H.L. Preparation of well-developed mesoporous activated carbon fibers from plant pulp fibers and its adsorption of methylene blue from solution. Chem. Phys. Lett. 2021, 771, 138535. [Google Scholar] [CrossRef]
- Skodras, G.; Diamantopoulou, I.; Pantoleontos, G.; Sakellaropoulos, G.P. Kinetic studies of elemental mercury adsorption in activated carbon fixed bed reactor. J. Hazard. Mater. 2008, 158, 1–13. [Google Scholar] [CrossRef]
- Langmuir, I. The adsorption of gases on plane surfaces of glass, mica and platinum. J. Am. Chem. Soc. 1918, 40, 1361–1402. [Google Scholar] [CrossRef]
- Freundlich, H. Over the adsorption. J. Phys. Chem. 1906, 57, 385–470. [Google Scholar]
- Hu, Z.; Chen, H.; Ji, F.; Yuan, S. Removal of Congo Red from aqueous solution by cattail root. J. Hazard. Mater. 2010, 173, 292–297. [Google Scholar] [CrossRef] [PubMed]
- Zhang, Z.; Moghaddam, L.; O’Hara, I.M.; Doherty, W.O. Congo Red adsorption by ball-milled sugarcane bagasse. Chem. Eng. J. 2011, 178, 122–128. [Google Scholar] [CrossRef]
- Gedam, V.V.; Raut, P.; Chahande, A.; Pathak, P. Kinetic, thermodynamics and equilibrium studies on the removal of Congo red dye using activated teak leaf powder. Appl. Water Sci. 2019, 9, 55. [Google Scholar] [CrossRef]
- Hayati, B.; Mahmoodi, N.M.; Maleki, A. Dendrimer–titania nanocomposite: Synthesis and dye-removal capacity. Res. Chem. Intermed. 2015, 41, 3743–3757. [Google Scholar] [CrossRef]
- Li, M.; Luo, J.; Lu, J.; Shang, W.; Mu, J.; Sun, F.; Dong, Z.; Li, X. A novel nanofibrous PAN ultrafiltration membrane embedded with ZIF-8 nanoparticles for effective removal of Congo red, Pb (II), and Cu (II) in industrial wastewater treatment. Chemosphere 2022, 304, 135285. [Google Scholar] [CrossRef] [PubMed]
- Borse, S.; Temgire, M.; Khan, A.; Joshi, S. Photochemically assisted one-pot synthesis of PMMA embedded silver nanoparticles: Antibacterial efficacy and water treatment. RSC Adv. 2016, 6, 56674–56683. [Google Scholar] [CrossRef]
- Devi, T.B.; Mohanta, D.; Ahmaruzzaman, M. Biomass derived activated carbon loaded silver nanoparticles: An effective nanocomposite for enhanced solar photocatalysis and antimicrobial activities. J. Ind. Eng. Chem. 2019, 76, 160–172. [Google Scholar] [CrossRef]
- Karthik, C.; Radha, K.V. Silver nanoparticle loaded activated carbon: An escalated nanocomposite with antimicrobial property. Orient. J. Chem. 2016, 32, 735–741. [Google Scholar] [CrossRef]
- Taha, A.; Ben Aissa, M.; Da’na, E. Green synthesis of an activated carbon-supported Ag and ZnO nanocomposite for photocatalytic degradation and its antibacterial activities. Molecules 2020, 25, 1586. [Google Scholar] [CrossRef]
- AbdEl-Salam, A.H.; Ewais, H.A.; Basaleh, A.S. Silver nanoparticles immobilised on the activated carbon as efficient adsorbent for removal of crystal violet dye from aqueous solutions. A kinetic study. J. Mol. Liq. 2017, 248, 833–841. [Google Scholar] [CrossRef]
- Obayomi, K.S.; Lau, S.Y.; Akubuo-Casmir, D.; Yahya, M.D.; Auta, M.; Bari, A.F.; Oluwadiya, A.E.; Obayomi, O.V.; Rahman, M.M. Adsorption of endocrine disruptive Congo red onto biosynthesized silver nanoparticles loaded on hildegardia barteri activated carbon. J. Mol. Liq. 2022, 352, 118735. [Google Scholar] [CrossRef]
- Ramana, D.V.; Yu, J.S.; Seshaiah, K. Silver nanoparticles deposited multiwalled carbon nanotubes for removal of Cu (II) and Cd (II) from water: Surface, kinetic, equilibrium, and thermal adsorption properties. Chem. Eng. J. 2013, 223, 806–815. [Google Scholar] [CrossRef]
- Ali, O.I.; Zaki, E.R.; Abdalla, M.S.; Ahmed, S.M. Mesoporous Ag-functionalized magnetic activated carbon-based agro-waste for efficient removal of Pb (II), Cd (II), and microorganisms from wastewater. Environ. Sci. Pollut. Res. 2023, 30, 53548–53565. [Google Scholar] [CrossRef]
- Neme, I.; Gonfa, G.; Masi, C. Castor seeds hull activated carbon impregnated with silver nanoparticles for removal of Escherichia coli from water. Case Stud. Chem. Environ. Eng. 2023, 7, 100320. [Google Scholar] [CrossRef]
- Nyirenda, J.; Kalaba, G.; Munyati, O. Synthesis and characterization of an activated carbon-supported silver-silica nanocomposite for adsorption of heavy metal ions from water. Results Eng. 2022, 15, 100553. [Google Scholar] [CrossRef]

| Sample | SBET (m2 g−1) | VT (cm3 g−1) | DAvg (nm) | T Area (m2 g−1) |
|---|---|---|---|---|
| KF | 3.2 | 0.000 | 5.50 | 0.00 |
| N1 KAC-CS-AgNPs | 204.4 | 0.003 | 3.20 | 8.30 |
| Model | Parameter | Cu2+ | Pb2+ | CR Dye | |
|---|---|---|---|---|---|
| Isotherm | Langmuir | qmax (mg g−1) | 79.37 | 78.13 | 80.65 |
| qexp (mg g−1) | 71.88 | 72.27 | 75.93 | ||
| b (L mg−1) | 0.773 | 0.977 | 1.638 | ||
| R2 | 0.928 | 0.950 | 0.997 | ||
| RL | 0.049 | 0.039 | 0.024 | ||
| Freundlich | Kf | 0.0387 | 0.0343 | 0.0267 | |
| 1/n | 0.524 | 0.469 | 0.394 | ||
| R2 | 0.993 | 0.996 | 0.992 | ||
| Kinetic | Pseudo-first order | (min−1) | −0.0153 | −0.0129 | −0.0114 |
| R2 | 0.863 | 0.904 | 0.940 | ||
| Pseudo-second order | K2 | 0.00058 | 0.00116 | 0.00131 | |
| qe (cal) mg g−1 | 72.46 | 77.52 | 80.65 | ||
| qe (exp) mg g−1 | 71.88 | 72.27 | 75.94 | ||
| R2 | 0.990 | 0.993 | 0.997 | ||
| Elovich | α (mg g−1 min−1) | 17.939 | 28.954 | 34.914 | |
| β (g mg−1) | 0.0680 | 0.0672 | 0.0636 | ||
| R2 | 0.973 | 0.967 | 0.972 | ||
| Adsorb-Ate | ΔS (kJ mol−1) | ΔH (kJ mol−1) | R2 | ΔG (kJ mol−1) | |||
|---|---|---|---|---|---|---|---|
| 300 K | 310 K | 320 K | 330 K | ||||
| Cu2+ | 31.9 | 3752 | 0.968 | −5744.3 | −6176.3 | −6518.2 | −6692.2 |
| Pb2+ | 67.2 | 10,369 | 0.978 | −9716.8 | −10,514.1 | −11,310.2 | −11,692.4 |
| CR dye | 26.9 | 1620 | 0.818 | −6320.8 | −6814.7 | −7161.7 | −7101.4 |
| Disinfectant | Diameter (mm) of Zone of Inhibition (ZoI) | |
|---|---|---|
| E. coli | S. aureus | |
| N1 KAC-CS-AgNPs | 12.0 | 10.0 |
| N2 KAC-CS-AgNPs | 12.0 | 9.0 |
| CS-AgNPs | 8.0 | 7.0 |
| AgNO3 (0.05 M) | 6.0 | 5.0 |
| Adsorbent | Dosage (g L−1) | Removal of Dyes and Metals (% Removal or Adsorption Capacity) | Microbial Pathogens (Zone of Inhibition) | Refs. | |||||
|---|---|---|---|---|---|---|---|---|---|
| Jute-ACNPs | 0.28 | NA | NA | NA | E. coli- 20 mm | P. aeruginosa 8 mm | B. subtilis 25 mm | S. aureus- 23 mm | [69] |
| Powder AC-AgNPs (Commercial) | NA | NA | NA | NA | E. coli-18 mm | P. aeruginosa NA | B. subtilis NA | *NA | [70] |
| Azadirachta indica (Neem)-ACAg/ZnO | 0.4 | NA | NA | NA | E. coli- 6 mm | P. aeruginosa 6 mm | B. subtilis NA | S. aureus-18 mm | [71] |
| AC-AgNPs | 0.1 | NA | NA | NA | E. coli NA | P. aeruginosa NA | B. subtilis NA | NA | [72] |
| Hildegardia barteri-AC-NPs | 1 | Congo red (qexp) 161.29 mg g−1 | NA | NA | E. coli NA | P. aeruginosa NA | B. subtilis NA | S. aureus NA | [73] |
| Ag NPs-MWCNT | 0.5 | NA | NA | Copper (qexp) 58.02 mg g−1 | E. coli NA | P. aeruginosa NA | B. subtilis NA | S. aureus NA | [74] |
| Magnetite @AC-AgNPs | 0.5 | NA | Lead (qexp) 75 mg g−1 | NA | E. coli 28 mm | P. aeruginosa NA | B. subtilis 25 mm | S. aureus NA | [75] |
| Ag-NPs-AC | 0.5 | Congo red (qexp) 66.7 mg g−1 | NA | NA | E. coli NA | P. aeruginosa NA | B. subtilis NA | S. aureus NA | [49] |
| Castor seed-AC-AgNPs | 2.0 | NA | NA | NA | E. coli 9.3 mm | P. aeruginosa NA | B. subtilis NA | S. aureus NA | [76] |
| AC-Ag-SiO2 nanocomposite | 1.0 | NA | Lead (qexp) 81.3 mg g−1 | Copper (qexp) 84.8 mg g−1 | E. coli NA | P. aeruginosa NA | B. subtilis NA | S. aureus NA | [77] |
| KAC-CS-AgNPs | 0.25 | Congo red (qexp) 75.9 mg g−1 | Lead (qexp) 72.3 mg g−1 | Copper (qexp) 71.5 mg g−1 | E. coli-12 mm | NA | NA | S. aureus-10 mm | This work |
Disclaimer/Publisher’s Note: The statements, opinions and data contained in all publications are solely those of the individual author(s) and contributor(s) and not of MDPI and/or the editor(s). MDPI and/or the editor(s) disclaim responsibility for any injury to people or property resulting from any ideas, methods, instructions or products referred to in the content. |
© 2023 by the authors. Licensee MDPI, Basel, Switzerland. This article is an open access article distributed under the terms and conditions of the Creative Commons Attribution (CC BY) license (https://creativecommons.org/licenses/by/4.0/).
Share and Cite
Mandal, S.; Hwang, S.; Marpu, S.B.; Omary, M.A.; Prybutok, V.; Shi, S.Q. Bioinspired Synthesis of Silver Nanoparticles for the Remediation of Toxic Pollutants and Enhanced Antibacterial Activity. Biomolecules 2023, 13, 1054. https://doi.org/10.3390/biom13071054
Mandal S, Hwang S, Marpu SB, Omary MA, Prybutok V, Shi SQ. Bioinspired Synthesis of Silver Nanoparticles for the Remediation of Toxic Pollutants and Enhanced Antibacterial Activity. Biomolecules. 2023; 13(7):1054. https://doi.org/10.3390/biom13071054
Chicago/Turabian StyleMandal, Sujata, Sangchul Hwang, Sreekar B. Marpu, Mohammad A. Omary, Victor Prybutok, and Sheldon Q. Shi. 2023. "Bioinspired Synthesis of Silver Nanoparticles for the Remediation of Toxic Pollutants and Enhanced Antibacterial Activity" Biomolecules 13, no. 7: 1054. https://doi.org/10.3390/biom13071054
APA StyleMandal, S., Hwang, S., Marpu, S. B., Omary, M. A., Prybutok, V., & Shi, S. Q. (2023). Bioinspired Synthesis of Silver Nanoparticles for the Remediation of Toxic Pollutants and Enhanced Antibacterial Activity. Biomolecules, 13(7), 1054. https://doi.org/10.3390/biom13071054

